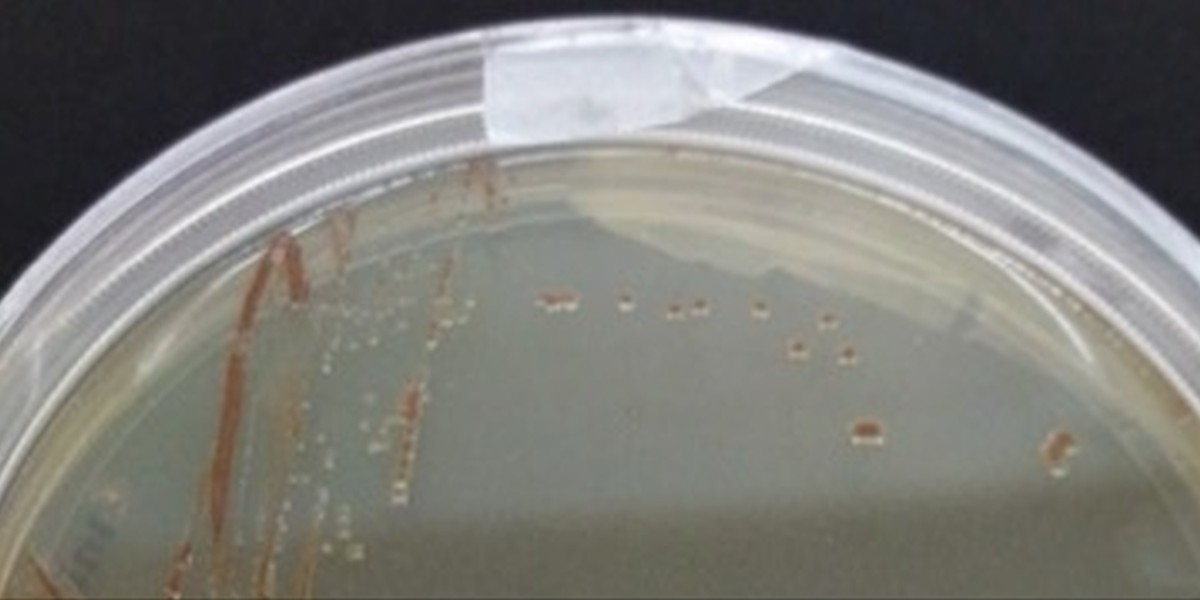

Microbiology
Studing the diversity, physiology, and activity of eukaryotes, prokaryotes, and viruses from diverse marine systems
We are interested in determining the effects of anthropogenic pressures (plastics, xenobiotics, eutrophication) on microorganisms, their adaptive response to those pressures, and how this impacts marine ecosystems, from the tropics to the poles. In addition, we are also interested in the role of marine microorganisms contributing to and alleviating climate change by the production or the consumption of greenhouse gases.